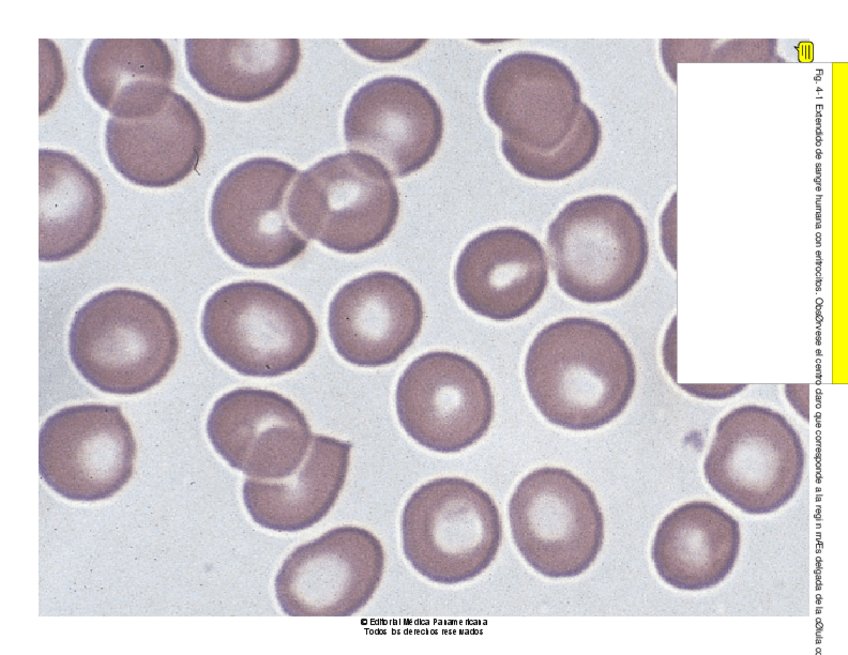

Biología Celular e Histología
apuntes
-
Apuntes con fotos y señalizaciones
He publicado nuevos apuntes de 1º Biología Celular e Histología: Apuntes con fotos y señalizaciones
He publicado nuevos apuntes de 1º Biología Celular e Histología: Esquemas-repaso-Histologia.pdf
He publicado nuevos apuntes de 1º Biología Celular e Histología: Esquemas-repaso-Histologia-T3.pdf
He publicado nuevos apuntes de 1º Biología Celular e Histología: HISTOLOGIA.pdf
He publicado nuevos apuntes de 1º Biología Celular e Histología: Sangre-tema-21.pdf
He publicado nuevos apuntes de 1º Biología Celular e Histología: Tema-11Biologia-celular-del-cancer.pdf
He publicado nuevos apuntes de 1º Biología Celular e Histología: Tema-10Control-de-la-diferenciacion-celular.pdf
He publicado nuevos apuntes de 1º Biología Celular e Histología: Tema-9Senalizacion-celular.pdf
He publicado nuevos apuntes de 1º Biología Celular e Histología: Tema-8Ciclo-celular.pdf
He publicado nuevos apuntes de 1º Biología Celular e Histología: Tema-7Citoesqueleto-y-movimiento-celular-20-21.pdf
He publicado nuevos apuntes de 1º Biología Celular e Histología: biologia-apuntes.pdf
He publicado nuevos trabajos de 1º Biología Celular e Histología: Seminario-1.pdf
He publicado nuevos trabajos de 1º Biología Celular e Histología: Seminario-1.2.pdf
He publicado nuevos practicas de 1º Biología Celular e Histología: PRACTICAS-HISTOLOGIA-2.pdf
He publicado nuevos practicas de 1º Biología Celular e Histología: PRACTICAS-HISTOLOGIA.pdf
He publicado nuevos practicas de 1º Biología Celular e Histología: Practicas-histologia-2.pdf
He publicado nuevos practicas de 1º Biología Celular e Histología: Practica-3.pdf
He publicado nuevos apuntes de 1º Biología Celular e Histología: HISTOLOGIA T 6-7-8-9-10-11-12-13.pdf
He publicado nuevos apuntes de 1º Biología Celular e Histología: HISTOLOGIA T 4-5.pdf
He publicado nuevos apuntes de 1º Biología Celular e Histología: HISTOLOGIA T 14-15-16-17.pdf
He publicado nuevos apuntes de 1º Biología Celular e Histología: HISTOLOGIA T 2-3.pdf
He publicado nuevos apuntes de 1º Biología Celular e Histología: HISTOLOGIA T 1.pdf
He publicado nuevos apuntes de 1º Biología Celular e Histología: Histologia-odontologica.pdf
He publicado nuevos examenes de 1º Biología Celular e Histología: 2o-Parcial-resuelto.-Histologia.pdf
He publicado nuevos apuntes de 1º Biología Celular e Histología: 11.-Biologia-celular-del-cancer.pdf
He publicado nuevos apuntes de 1º Biología Celular e Histología: 10.-Diferenciacion-celular-y-formacion-de-tejidos.pdf
He publicado nuevos apuntes de 1º Biología Celular e Histología: 9.-Senalizacion-celular.pdf
He publicado nuevos apuntes de 1º Biología Celular e Histología: 8.-Ciclo-celular.pdf
He publicado nuevos apuntes de 1º Biología Celular e Histología: 6.-Bioenergetica-y-Metabolismo.pdf
He publicado nuevos apuntes de 1º Biología Celular e Histología: 7.-Citoesqueleto-y-movimiento-celular.pdf
He publicado nuevos apuntes de 1º Biología Celular e Histología: 4.-El-nucleo.pdf
He publicado nuevos apuntes de 1º Biología Celular e Histología: 5.-Distribucion-y-transporte-de-proteinas.pdf
He publicado nuevos apuntes de 1º Biología Celular e Histología: 3.-Las-membranas-celulares.pdf
He publicado nuevos apuntes de 1º Biología Celular e Histología: 2.-Origen-y-Evolucion-Celular.pdf
He publicado nuevos apuntes de 1º Biología Celular e Histología: 1.-Introduccion-a-la-Biologia-Celular.pdf
He publicado nuevos examenes de 1º Biología Celular e Histología: 2o-Parcial-resuelto.pdf
He publicado nuevos examenes de 1º Biología Celular e Histología: PARCIAL-HISTOLOGIA-2019.pdf
examenes
-
Biología e Histología
He publicado nuevos examenes de 1º Biología Celular e Histología: Biología e Histología

¡Estás al día!
Has visto todos los archivos